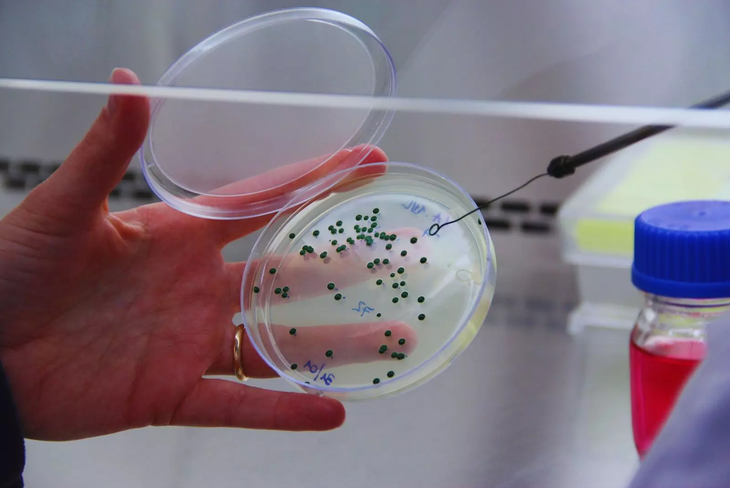

¿Una levadura del INTA es el secreto del éxito del Malbec argentino en el mundo?
¿Puede una levadura nativa mendocina conquistar paladares en Francia e Italia? Lalvin Tango lo logra, duplicando exportaciones y elevando el Malbec a icono global
En un hito para la enología argentina, las exportaciones de la levadura Lalvin Tango, desarrollada por el Instituto Nacional de Tecnología Agropecuaria (INTA), se duplicaron en los últimos cinco años. Según datos precisos, pasaron de 833 kilos en 2018 a 1935 kilos en 2023, representando un crecimiento del 132%. Esta cepa de Saccharomyces cerevisiae, seleccionada en los viñedos del INTA La Consulta en Mendoza, se ha posicionado como una herramienta esencial para potenciar el perfil sensorial de varietales emblemáticos como el Malbec.
Hoy, Lalvin Tango se exporta a más de 14 países, incluyendo potencias vinícolas como Estados Unidos, Francia, Italia, Alemania, Austria, España y Portugal. Este éxito no solo valida la investigación aplicada del INTA, sino que resalta la capacidad argentina para innovar en biotecnología enológica, compitiendo en igualdad con levaduras importadas tradicionalmente dominantes.
Mariana Combina, investigadora del INTA y del Conicet, líder del Laboratorio de Microbiología Enológica del INTA Mendoza, explica el origen: “Cuando se definió que el Malbec era nuestro vino emblema, nos dimos cuenta de que las levaduras que usábamos eran importadas. Eso hacía que perdiéramos características únicas del Malbec argentino. Entonces seleccionamos una levadura propia que potenciara los aromas de frutos rojos, mantuviera la acidez y aportara untuosidad en boca”.
Viñedos mendocinos en La Consulta: cuna de Lalvin Tango, la levadura que duplica exportaciones del INTA y realza el Malbec argentino. Foto: INTA
Diseño sensorial: Cómo Tango sintetiza la esencia argentina
El aroma del vino se compone de tres pilares: primario (de la uva), secundario (aportado por la levadura) y terciario (desarrollado en crianza). Lalvin Tango fue engineered para maximizar el secundario, conservando el carácter distintivo del Malbec: notas intensas de frutos rojos, equilibrio ácido y untuosidad en boca. El proceso involucró años de ensayos en bodegas, donde la cepa demostró excelentes propiedades fermentativas, reforzando la expresión frutal sin alterar el equilibrio.
“Seleccionamos esta levadura de unos viñedos en La Consulta y la transferimos a una empresa multinacional que la produce y comercializa”, detalla Combina. Aunque el orgullo es evidente por su adopción global, surge un llamado a la acción: “Soñamos con que exista una industria nacional que la produzca, para agregar valor en origen y beneficiar directamente a los productores locales”. Este modelo de transferencia tecnológica resalta el rol del INTA en la cadena de valor, pero también evidencia oportunidades para escalar producción local y retener mayor margen económico en Argentina.
De 833 kg en 2018 a 1935 kg en 2023: el boom exportador de Tango conquista 14 países, incluyendo Francia e Italia. Foto: INTA
Hacia levaduras autóctonas: Identidad territorial en cada cepa
El triunfo de Tango es solo el comienzo. El INTA avanza en la selección de levaduras nativas y autóctonas, microorganismos que conviven naturalmente en viñedos regionales, para variedades como Bonarda o criollas (torrontés riojano, criolla grande, cereza, moscatel rosado). “Cada levadura tiene una huella que se traduce en el perfil sensorial del vino”, afirma Combina. Estas cepas permiten elaborar vinos con expresión territorial, reflejando diversidad climática, edáfica y cultural.
Con más de una década de trabajo, el INTA recupera variedades criollas mediante vinos piloto en su bodega experimental. Se exploran consorcios de levaduras Saccharomyces y no Saccharomyces, replicando la biodiversidad microbiana del viñedo para obtener complejidad y expresividad superior. Todos los aislados se preservan en la Colección de Microorganismos del INTA Mendoza (CoMIM), registrada bajo protocolos internacionales, posicionando a Argentina como referente en patrimonio biotecnológico enológico.
Mariana Combina en el lab: seleccionando levaduras autóctonas para bonarda y criollas, forjando identidad territorial. Foto: INTA
Innovación circular: Del territorio al mundo y de vuelta
“Desde el INTA impulsamos un modelo de innovación que nace en el territorio y vuelve a él en forma de valor”, concluye Combina. Cada levadura narra una historia única: suelo, clima, vid y manos humanas. Con Tango abriendo mercados y nuevos desarrollos en pipeline, el INTA consolida una vitivinicultura argentina de carácter, identidad y calidad global. Este enfoque no solo eleva el Malbec, sino que fortalece la soberanía biotecnológica, invitando a bodegas y enólogos a explorar levaduras locales para diferenciarse en un mercado saturado.
En resumen, el duplicado de exportaciones de Lalvin Tango –de 833 kg a 1935 kg– subraya el potencial de la investigación. Para enólogos especializados, representa una herramienta probada; para la industria, un catalizador para invertir en autóctonas. El futuro: vinos que no solo se beban, sino que se sientan como argentinos.
Fuente: INTA con aportes de +P
En esta nota